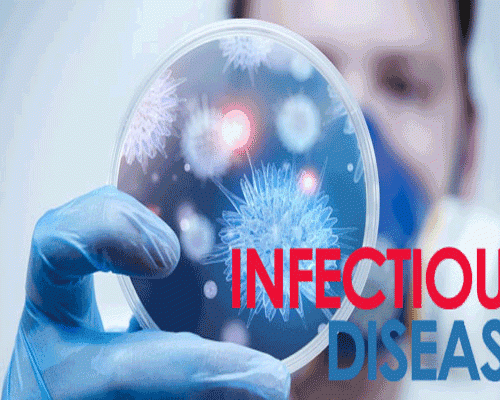

கூந்தல் பாதுகாப்புக்கு ஒருசில பயனுள்ள டிப்ஸ்
செவ்வாய், 21 மார்ச் 2017
மருந்து, மாத்திரையே மரணத்திற்கு காரணமாகுமா?
செவ்வாய், 21 மார்ச் 2017
தொற்று நோய்கள் பரவ என்ன காரணம்?
செவ்வாய், 21 மார்ச் 2017
வீட்டிலேயே முகத்திற்கு தக்காளி பேஷியல் செய்வது எப்படி?
திங்கள், 20 மார்ச் 2017
கேன் வாட்டரில் உள்ளது நல்ல தண்ணீர் தானா?
வெள்ளி, 17 மார்ச் 2017
இரத்த சோகைக்கு (Anemia) அக்குபஞ்சரில் தீர்வு!
வெள்ளி, 17 மார்ச் 2017
பப்ளிக் டாய்லெட்டை பயன்படுத்த போகிறீர்களா? இதை முதலில் கவனியுங்கள்
வெள்ளி, 17 மார்ச் 2017
தொப்பை என்றால் என்ன? தொப்பையை குறைப்பது எப்படி?
வெள்ளி, 17 மார்ச் 2017
பூச்சிவிரட்டிகள் பூச்சியை மட்டுமா விரட்டுகிறது? ஆரோக்கியத்தையும் சேர்த்து அல்லவா!!
வியாழன், 16 மார்ச் 2017
புற்றுநோய்க்கு புகையிலை மட்டும் காரணமா? ஒரு அதிர்ச்சி ஆய்வு
வியாழன், 16 மார்ச் 2017
இரவு ஷிப்ட் வேலை செய்பவர்கள் கண்டிப்பாக கடைபிடிக்க வேண்டிய வழிமுறைகள்
புதன், 15 மார்ச் 2017
மொபைல் போனுக்கும் சர்க்கரை நோயுக்கும் என்ன சம்மந்தம்? திடுக்கிட வைக்கும் ஆய்வு
புதன், 15 மார்ச் 2017
நல்ல தூக்கம் பெற ஐந்து வழிகள்
செவ்வாய், 14 மார்ச் 2017
காலை உணவை தவிர்ப்பதால் என்னென்ன பிரச்சனைகள் ஏற்படும் தெரியுமா?
ஞாயிறு, 12 மார்ச் 2017
இயற்கை ஆண்டிபயாடிக்ஸ் எவை எவை என தெரியுமா?
வியாழன், 9 மார்ச் 2017
படுக்கை அறையில் என்னென்ன இருக்க வேண்டும்?
செவ்வாய், 7 மார்ச் 2017
கண்ணாடி வாங்க போகிறீர்களா? அதற்கு முன்பு இதை படியுங்கள்
திங்கள், 6 மார்ச் 2017
ஆர்கானிக் முறையில் தலைமுடியை சிவப்பாக மாற்ற வேண்டுமா?
புதன், 15 பிப்ரவரி 2017
